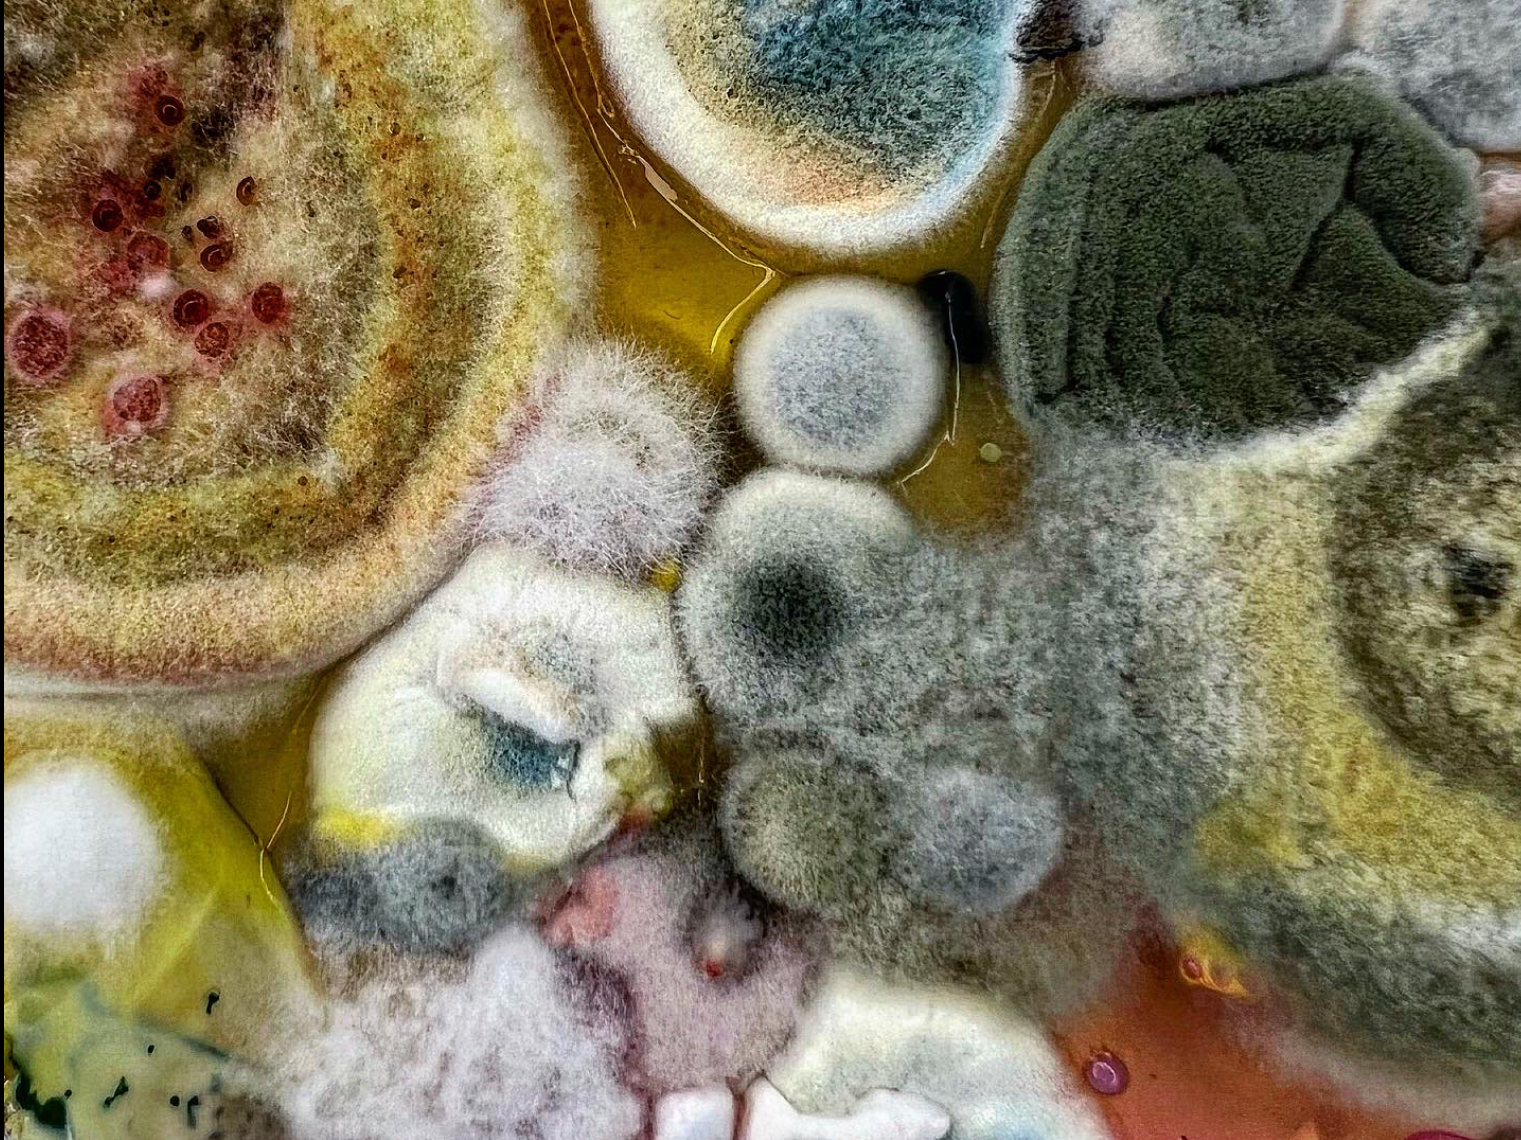

Branding

AXIOM™ visual

Branding
Logotype vol.1

Logotype vol.2
